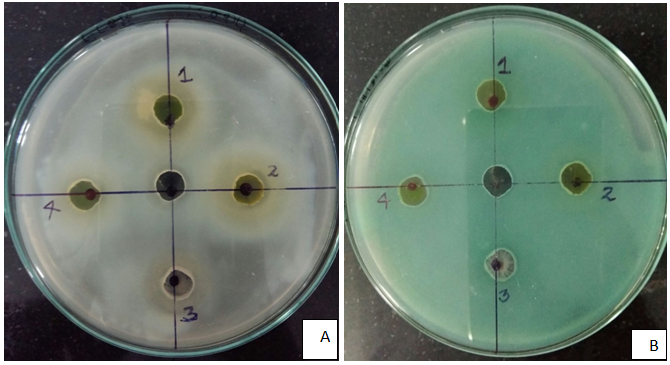

Dept. of Biotechnology, Mithibai College, Mumbai
Email: jayaprdachunduri@gmail.com
Received: 19 Jul 2016, Revised and Accepted: 20 Aug 2016
ABSTRACT
Objective: phytochemical screening and antioxidant activity analyses of selected indoor plants and to evaluate commercial applications.
Methods: Qualitative and quantitative phytochemical analyses of alcoholic and aquatic crude extracts of leaves of selected non-flowering indoor plants were assessed using standard protocols and later compared with FTIR analyses. Antioxidant and antibacterial activities of the extracts were studied
Results: Phytochemical analysis of polar solvent extractions of the four selected plants Pedilanthus tithymaloides, Cordyline terminalis, Tradescantia zebrine and Rhoeo discolou. Indicated the presence of tannins in all four varieties terpenoids in 3, flavonols, phytosterols and phenols in two plants, followed by alkaloids. The phytochemical analyses were supported by FTIR reports. Quantitative studies indicated variations in flavonol, tannin and phenols concentrations among the four species. High concentrations of Total flavonols (P. tithymaloides) and Tannins (C. terminalis) were observed. C. terminalis extract showed comparatively highest reducing power followed by R. discolour and P. tithymaloides extracts. Antibiotic Sensitivity Testing indicated P. tithymaloides showed a maximum zone of inhibition compared to R. discolor. C. terminalis plant leaf extract showed a faint zone of inhibition against E. fecalis while others couldnot. Intense colors of C. terminalis and T. zebrine plants could be used as a natural dye as well as pH indicator.
Conclusion: The rich concentrations of the tannins from non-flowering indoor plants could be the future option of dyes and dyeing industry as natural colorants as well as pH indicators. These plants were rich sources of phytochemicals (phenols, flavonols, tannins, and phytosterols), with antioxidant and antibacterial activity.
Keywords: Aesthetic, Phytochemical screening, FTIR, Phytosterol, Flavonoids
© 2016 The Authors. Published by Innovare Academic Sciences Pvt Ltd. This is an open access article under the CC BY license (http://creativecommons.org/licenses/by/4.0/)
DOI: http://dx.doi.org/10.22159/ijcpr.2016v8i4.15275
INTRODUCTION
Plants contribute a major part in the biodiversity on the earth. Plants are rich resources of ingredients which can be utilized in drug development and synthesis as well as herbal medicines; examples include laxatives, blood thinners, antibiotics and anti-malaria medications. The active ingredients viz. Taxol, vincristine and morphine isolated from foxglove, periwinkle, yew and opium poppy respectively [1]. Researchers have found that people in different parts of the world tend to use the same or similar plants for treating the same illnesses but in different combinations [2]. Non-flowering plants which can be vegetatively propagated have been popular in tropical gardens for centuries. Crotons grow into shrubs and small trees in their native habitats of India, Malaysia and some of the South Pacific islands. Leaf colors range from reds, oranges, and yellows to green with all combinations of variegated colors. Leaf shapes vary from broad and elliptical to narrow and almost linear. Since some cultivars are quite tolerant of interior environments, crotons have become very popular as interior potted foliage plants and excellent material for use in floral arrangements [3]. Evaluation and characterization of plants and plant constituents against a number of diseases based on their traditional claims of the plants given in Ayurveda have become part of the research of today [4]. The phytochemical analysis of the plants is very important commercially and has great interest for pharmaceutical companies to produce new drugs to cure various diseases [5]. Plants are a source of natural colorants which can use as textiles inks, paints and cosmetics [6]. The current study is aimed at studying the phytochemical analysis of selected indoor ornamental plants and explore possible applications as a source of drugs, dying colorants, pH indicators in addition to their aesthetic appearance in future. These selected plants were considered due to the easy cultural practices and their low preferences during the cultivation conditions as given below
Euphorbia tithymaloides (Devil's Backbone)
Family: Euphorbiaceae
Botanical Name: Pedilanthus tithymaloides 'Variegatus'
Plant common name: Japanese Poinsettia, Variegated Devil's Backbone.
Leaves are alternate, simple, lanceolate, glabrous, and 1.5’’to 3.0’’long with acuminate tips and sessile bases, and undulate to entire margins. Leaf color varies from green to green flushed red depending on the species type, Easily recognized by its rubbery, slightly zig-zagging stems. Growing Conditions are any type of soil, with good drainage, Soil type can be loam, sand and can tolerate pollution, Drought as well as Salty condition. Foliage colour varies with season [7].
Tradescantia zebrine
Common Name: inch plant
Family: Commelinaceae
Herbaceous perennial, belongs to southern Mexico, Belzium, Guatemala, Honduras, with colorful leaves, with low water requirement and maintenance. It is a very popular trailing plant. This plant is synonymous with T. pendula and Zebrina pendula. It is also sometimes commonly called inch plant, although that name is usually reserved for T. fluminensis. T. zebrine can survive without much light at all. The leaves colors will be less intense more green at least filtered sun (full sun preferred), and it takes a lot of light to get the purple color.
Rhoeo discolour
Family: Commelinaceae
Synonyms: Rhoeo discolour, Rhoeo spathacea, Tradescantia spathacea, T. discolour
The plant is tropical and tender and perennial. Foliage colour can be burgundy or bronze-green. Rhoeo discolor is a legendary plant used for treatment of superficial mycoses in Mexican traditional medicine. Despite its extended use, it is not known whether it has side-effects. An crude ethanolic extract from R. discolor was prepared, its mutagenic capacity was investigated by the Ames test, and its genotoxic activity in primary liver cell cultures using the unscheduled DNA synthesis assay. A free radical scavenging test was used in order to explore the antioxidant capacity of R. discolor extract, as compared with three commercial well-known antioxidants quercetin, ascorbic acid and tocopherol. R. discolor extract showed less radical scavenging effect than quercetin, but similar to that of alpha-tocopherol and more than ascorbic acid. It is important to note that this extract was neither mutagenic in S. typhimurium nor genotoxic in liver cell culture, even at concentrations as high as four and 166-fold of those needed for maximal anti-mutagenic or chemoprotective activities [8]. The extracts of this plant proved as antibacterial [9, 10].

Fig. 1: Selected indoor plants for phytochemical screening and their applications, (1). Pedilanthus tithymaloides; (2) Tradescentia zebrine; (3) Rhoeo discolour; (4) Cordyline terminalis (Dracena)
Cordyline terminalis (Dracena)
Common Name: Dracena kiwi, red palmita, dracenia
Scientific Name: Cordyline terminalis
Family: Agavaceae
This plant is originated at Tropic of Asia. Shrub vertical development, evergreen, little branched and issuing basal shoots. Broadly lanceolate, smooth leaves, 30-6 cm long, with yellow spots and pink edges. It requires frequent watering and fertilization in irrigation water. Multiplication is by cuttings or air layering. It develops in porous substrates, with high moisture and aeration. Controls pests and diseases such as cochineal, aphids and fungal diseases. It is very attractive interior, it must be placed near the windows. In hot and rainy weather is frequently found in gardens.
MATERIALS AND METHODS
Plant material
Four non-flowering indoor plants have been selected from nurseries and indoor locations of Maharashtra and Andhra Pradesh. The taxonomic identification of plants was carried out by Dr,Sashirekha of Botany department, Mithibai College, The four species were identified as Tradescantia zebrine, Cordyline terminalis, Rhoeo discolour, Pedilanthus tithymaloides. Collected plant material was thoroughly washed and then dried under shade at 25±2 °C for about 10 d. The dried plant samples were ground well into a fine powder in a mixer grinder. The powdered samples were then stored at room temperature.
Preparation of plant extract
Thoroughly washed plant leaves about 50g were crushed using mortar and pestle using 100 ml methanol as the solvent. The crushed sample was filtered using a muslin cloth and the filtrate was collected and then used for further procedures.
Chemicals and reagents
All Chemicals were obtained from commercial sources and were of analytical grade. Gallic acid and ascorbic acid were purchased from Loba Chemie Pvt. Ltd., Mumbai and quercetin, from Sigma-Aldrich, Bangalore. Sodium carbonate, sodium hydroxide, ferric chloride, potassium dichromate, lead acetate, sodium nitrite, aluminum chloride, sodium phosphate and ammonium molybdate were purchased from Himedia Laboratories Pvt. Ltd., Mumbai. All solvents are used as purchased. Sulphuric acid was purchased from Merck Specialities Pvt. Ltd., Mumbai
Phytochemical screening
Phytochemical examinations were carried out for all the extracts as per the standard methods [11].
1. Detection of alkaloids: Extracts were dissolved individually in dilute Hydrochloric acid and filtered.
a) Mayer’s Test: Filtrates were treated with Mayer’s reagent (Potassium Mercuric Iodide). Formation of a yellow coloured precipitate indicates the presence of alkaloids.
b) Wagner’s Test:. Formation of brown/reddish precipitate indicates the presence of alkaloids when filtrates were treated with Wagner’s reagent (Iodine in Potassium Iodide).
c) Dragendroff’s Test: Filtrates were treated with Dragendroff’s reagent (solution of Potassium Bismuth Iodide). Formation of red precipitate indicates the presence of alkaloids.
d) Hager’s Test: Presence of alkaloids confirmed by the formation of a yellow coloured precipitate when filtrates were treated with Hager’s reagent (saturated picric acid solution).
2. Detection of saponins
a) Froth Test: Extracts were diluted with distilled water to 20 ml and this was shaken in a graduated cylinder for 15 min. Formation of 1 cm layer of foam indicates the presence of saponins.
b) Foam Test: 0.5 gm of the extract was shaken with 2 ml of water. If foam produced persists for ten minutes, it indicates the presence of saponins.
3. Detection of phytosterols
a) Salkowski’s Test: Extracts were treated with chloroform and filtered. The filtrates were treated with few drops of Conc. Sulphuric acid, shaken and allowed to stand. The appearance of golden yellow colour indicates the presence of triterpenes.
b) Libermann Burchard’s test: Extracts were treated with chloroform and filtered. The filtrates were treated with few drops of acetic anhydride, boiled and cooled. Conc. Sulphuric acid was added. Formation of the brown ring at the junction indicates the presence of phytosterols.
4. Detection of phenols
Ferric Chloride Test: Extracts were treated with 3-4 drops of ferric chloride solution. Formation of bluish black colour indicates the presence of phenols.
5. Detection of tannins Gelatin Test: To the extract, 1% gelatin solution containing sodium chloride was added. Formation of white precipitate indicates the presence of tannins.
6. Detection of flavonoids
a) Alkaline Reagent Test: Extracts were treated with few drops of sodium hydroxide solution. Formation of intense yellow colour, which becomes colorless on the addition of dilute acid, indicates the presence of flavonoids.
b) Lead acetate Test: Extracts were treated with few drops of lead acetate solution. Formation of yellow colour precipitate indicates the presence of flavonoids [4].
7. Test for terpenoids
An amount of 0.8 g of selected plant sample was taken in a test tube, then poured 10 ml of methanol in it, shaken well and filtered to take 5 ml extract of plant sample. Then 2 ml of chloroform were mixed in the extract of selected plant sample, and 3 ml of sulphuric acid were added in selected sample extract. Formation of reddish brown color indicates the presence of terpenoids in the selected plants.
8. Test for flavonoids
For the confirmation of flavonoid in the selected plants, 0.5 g of each selected plant extract were added in a test tube and 10 ml of distill water, 5 ml of dilute ammonia solution were added to a portion of the aqueous filtrate of each plant extract followed by addition of 1 ml concentrated H2S04. An indication of yellow color shows the presence of flavonoid in each extract.
9. Test for alkaloids
For the purpose of phytochemical analysis of the selected plants, 0.2 g of the selected plant samples were added in each test tube and 3 ml of hexane were mixed in it, shaken well and filtered. Then took 5 ml of 2% HCl and poured in a test tube having the mixture of plant extract and hexane. Heated the test tube having the mixture, filtered it and poured few drops of picric acid in a mixture. Formation of yellow color precipitate indicates the presence of alkaloids [5].
Quantitative analyses by UV Spectrophotometry
Total flavonoid content aluminum chloride colorimetric assay method
Total flavonoid contents were measured using the aluminum chloride colorimetric assay. Methanolic extracts (400μg/ml) and standard solution of Quercetin (10-100μg/ml) different concentrations were added to 10 ml volumetric flask containing 4 ml of water [12]. To the above mixture, 0.3 ml of 5% NaNO2 was added. After 5 min, 0.3 ml of 10% AlCl3 was added. After 6 min, 2 ml of 1 M NaOH was added and the total volume was made up to 10 ml with distilled water. Then the solution was mixed well, and the absorbance was measured against a freshly prepared reagent blank at 510 nm. Total flavonoid content of the extracts was expressed as a percentage of Quercetin equivalent per 100 g dry weight of the sample.
Estimation of tannins (Folin Denis method)
1. Folin-Denis reagent: To 750 ml of water, 100 gm of sodium tungstate was added. 20 gm of phosphomolybdic acid and 50 ml of 85% phosphoric acid were also added. The whole mixture was refluxed for 2 h. It was cooled and diluted to 1000 ml.
2. Saturated sodium carbonate solution: 35 gm of anhydrous sodium carbonate was dissolved in 10 ml of water at 70-80oC and cooled overnight. The Clear liquid was decanted and used.
3. Standard solution: 100 mg of tannic acid was dissolved in 1 liter of water. Fresh solutions were prepared for each test.
4. Preparation of Sample
5 gm of sample was boiled with 400 ml of water for 30 min. The extract was cooled and transferred to 500 ml flask and made up to the volume.
Procedure
10 ml of standard solution was made up to 100 ml distilled water. 1-10 ml aliquots were taken in clear test tubes. 0.5 ml of Folin-Denis reagent and one ml of sodium carbonate solution was added to each tube. Each tube was made up to 10 ml with distilled water. All the reagents in each tube were mixed well and kept undisturbed for about 30 min and read at 760 nm against reagent blank. An aliquot of the sample extract containing not more than 0.1 mg of tannic acid was used and the percentage of tannin was determined using standard equation. The tannin concentration of the sample was determined by the standard graph of the tannic acid solution [13].
Determination of total phenols (Folin Ciocalteau Method)
The concentration of phenolics in plant extracts was determined using spectrophotometric method [14]. A methanolic solution of the extract in the concentration of 1 mg/ml was used in the analysis. The reaction mixture was prepared by mixing 0.5 ml of a methanolic solution of extract, 2.5 ml of 10% Folin-Ciocalteu’s reagent dissolved in water and 2.5 ml 7.5% NaHCO3. Blank was concomitantly prepared, containing 0.5 ml methanol, 2.5 ml 10% Folin-Ciocalteu’s reagent dissolved in water and 2.5 ml of 7.5% of NaHCO3. The samples were incubated in a thermostat at 45 °C for 45 min. The absorbance was determined using spectrophotometer at λmax = 765 nm. The samples were prepared in triplicate for each analysis and the mean value of absorbance was obtained. The same procedure was repeated for the standard solution of gallic acid, and the calibration line was construed. Based on the measured absorbance, the concentration of phenolics was read (mg/ml) from the calibration line; then the content of phenolics in extracts was expressed in terms of gallic acid equivalent (mg of GA/g of extract).
FT-IR spectrum analysis
FT-IR of the selected plant sample was carried out by the standard procedure [15]. Methanolic extracts of the leaves were prepared by crushing 5g of the powdered sample in 5 ml of methanol. The extract was dried for 3-4 d and the dry extract was subjected to FT-IR to screen for various phytochemical functional groups.
Antimicrobial activity
Antibacterial activity of the plant extracts was measured using agar cup technique [16] on selected bacterial strains
Preparation of extracts
Powdered air-dried plant leaves were considered for extraction with methanol. The crude methanol extract was prepared by maceration of plant leaf material (5g) with methanol (10 ml). The extract was filtered and evaporated to dryness in a vacuum.
Bacterial strains
All bacterial strains used in this study were laboratory strains. Each bacterial strain was inoculated on Nutrient agar medium. The bacterial species considered for this study were overnight cultures of Escherichia coli and E. fecalis.
Antibacterial testing
Antibacterial activity was measured using agar cup technique [16]. Briefly, the plant leaves were dissolved in methanol hence the final methanolic extracts were used. The culture was grown on nutrient agar slant at 37 °C for 24 h. The 18hr old culures were set at an absorbance of 0.05 using saline. 0.1 ml of inoculum was spread on nutrient agar plate using spread plate method. Cups were made using 10 mm diameter the cork borer and filled with 15 µl of the methanol extracts using a micropipetter with strile tips. Plates were incubated at 37 °C for 24 h. [17] and the results were observed.
Dyeing
Dyeing was performed using the pre-mordant technique. The muslin cloth was pre-treated with a mordant which is 4% Tannic acid for an hour at 60 °C. The treated cloth was dyed using the plant extract for 4 h. The cloth was treated with Stannous Chloride solution for half hour after the treatment with plant extract.
The dying material was prepared using standard techniques. Plant material was chopped into small pieces and boiled in double the amount of water and simmer for about an hour and strained. Before dyeing the facbrick was soaked in a fixative (Tannic acid) and dried. Pretreated fabric (Muslin, silk, cotton and wool work) was added to the dye solution and soaked overnight for a stronger shade [6].
pH indicator
Leaves of Cordyline terminalis spp and Rhoeo discolor were considered for identifying their capability as an acid-base indicator based on the Indicator test. 2-6 grams of finely cut plant sample was added with 10 ml of extracting solvent (methanol) and store extracts in a vial.
Acid-base indicator test
Standard solutions of different concentrations of (HCl, NaOH and NaCl solutions to provide a pH range of 1-13) in recorded quantity were added to a spot plate. 1 or more drops of the extracts were added to the standard solutions using a medicine dropper. Compare the different extracts in terms of their ability to differentiate pH ranges keeping in view the same number of drops for all the test standards [18-20].
RESULTS AND DISCUSSION
Studies of the four different plant leaf extracts revealed variation with respect to their qualitative and quantitative composition of the phytochemicals. FT-IR analyses were carried to confirm the laboratory analyses. The extracts were also checked for other usages such as dyes and pH indicators.
Phytochemical analysis
The current study on four indoor ornamental plants such as Cordyline terminalis, Pedilanthus tithymaloides, Tradescentia zebrine and Rhoeo discolour revealed considerable differences in their phytochemical compositions. Phytochemical analyses of the leaf extracts in organic solvents were performed using standard protocols and the following results were obtained (table 1).
Table 1: Phytochemical screening of four selected ornamental plants leaf extracts
| Test | Cordyline terminalis | Pedilanthus tithymaloides | Tradescentia zebrine | Rhoeo discolour |
| Alkaloid | - | - | + | - |
| Phytosterol | + | - | - | + |
| Phenol | + | - | - | + |
| Tannin | + | + | + | + |
| Flavonoid | - | + | + | - |
| Terpenoids | + | - | + | + |
The study revealed that Cordyline terminalis and Rhoeo discolor leaf extracts indicated the presence of phytosterols, phenols, tannins and terpenoids. Pedilanthus tithymaloides leaf extracts comprised tannins and flavonols as phytochemical components. Tradescantia zebrine leaf extracts showed positive results for alkaloids, tannins, flavonols and terpenoids. [21] Total phenolic content and flavonoids aqueous leaf extract were determined spectrophotometrically using the tannic acid and standard quercetin calibration curves, respectively.
Phytochemical analysis indicated that tannins were present in all the four selected plant varieties; terpenoids in Cordyline terminalis, Tradescantia zebrina and Rhoeo. discolour; Phytosterols and phenols in C. terminalis and R. discolour; flavonols in Pedilanthus tithymaloides and T. zebrina and alkaloids in T. zebrina were present
Total flavonoids estimation of methanolic leaf extracts was carried out using Aluminium chloride colorimetric assay and the results were expressed as a percentage of Quercetin equivalent per 100 g dry weight of the sample. The overall values of flavonols varied from a low of 9.25 to a maximum of 11.75 mg % Quercentin equivalents. Total flavonoid contents of four indoor ornamental plants C. terminalis P. tithymaloides R. discolour and T. Zebrina-leaf extracts were 12.5 mg%, 11.75 mg%, 19.5 mg% and 9.25 mg% respectively. The above result indicated E. discolour rich in flavonols than others. T. zebrina leaf extracts contained less flavonoids as compared to P. Tithymaloides (fig. 2).
Tannins
Tannin was quantified in the selected four indoor plant leaf extracts using Folin-Denis Method using tannic acid as standard. The overall tannin values varied from 8 (P. tithymaloides) to 40 gm (C. Terminalis) of tannic acid equivalents mg/100 gm of the sample. The moderate concentration of tannins were observed in T. zebrine (18 mg) and R. discolor (12 mg) tannic acid equivalent per 100g of sample respectively (fig. 2).
Phenols
Phenols were estimated using Folin-Ciocalteau method and the colour development was compared with that of the standard. The standard (Gallic acid) was prepared in a gradient of 0.02-0.10 mcg/ml. The graph was extrapolated in order to find the concentration of the sample. The quantitative determination of the total phenolic content expressed as mg gallic acid equivalents per 100 g dry weight of the sample. TPC of methanolic extracts showed the highest values of 21.2 and 20 mg in C. terminalis and P. Tithymaloides respectively. However, the TPC values of leaf extracts observed in T. zebrine (7.2 mg) and R. discolour (13.6 mg GAE) comparatively low] (fig. 2)

Fig. 2: Quantitative analyses of selected phytochemical compounds of the selected indoor ornamental plants
Quantitative studies indicated variations in flavonols, tannin and phenols concentrations among the four species. Total flavonoid content was less in Zebrina leaf extracts as compared to Pedilanthus tithymaloides plant leaf extracts. Cordyline terminalis indicated higher concentrations of Tannins when compared to the other three varieties while Pedilanthus tithymaloides had least. The high value of phenolic content 7.28±0.18 µg of Gallic acid equivalent (GAE)/mg of dry leaf and flavonoids content of 9.13±0.32 µg of quercetin equivalent (QE)/mg of dry leaf were observed in the indoor plant leaves
Ferric reducing antioxidant power assay (FRAP)
In ferric reducing antioxidant power assay (FRAP), the reductive capabilities of the four croton species were detected and compared with Ascorbic acid. C. terminalis extract showed highest reducing power followed by R. discolour and P. tithymaloides. (fig. 3). However, the reducing capabilities of these plants were less compared to the standard Ascorbic acid concentrations.

Fig. 3: FRAP assay for the selected ornamental plants
FTIR fingerprinting analyses
The FTIR analyses of the leaf extracts of four selected indoor non-flowering plants generally called as croton plants showed variation in their peak patterns. The different phytochemicals components in the extract were identified based on the peaks. [15, 22-24]
Cordyline terminalis spectrum (fig. 4) indicated various peaks at different wavelengths of 3000,2420,2439,1804,1672,1472,1448,1336 and 1056 nm stretching frequency when compared with standard. The IR stretching frequency at 3000 nm could be due to the ammonium ion and methyl C-H stretching frequency. The band at 1804 nm was due to aromatic combination bands, acid halide group, Aryl carbonate, open chain acid anhydride and transition metal carbonyls. A strong peak at 1672 nm assigned the presence of Alkenyl C=C stretching, aromatic ring stretching and an open chain imino group. Non-appearance of any peak at 2260 nm region indicated the absence of cyanide group in the extract which characterized nontoxic nature of the plants. A peak at 1472 and 1448 nm confirmed the presence of Methyl bend, aromatic ring stretch, Carbonate ion,1 °, 2 ° and 3 °amine CN stretch while 1056 nm showed skeletal C-C vibrations,phosphate ion,silicate ion and CO stretch. This indicated the presence of phytosterol, phenol, tannin, terpenoids while flavonoids in a small amount.

Fig. 4: FTIR spectrum analysis of methanolic extract of C. terminalis
Pedilanthus tithymaloides extracts showed various peaks values (fig. 5) corresponds to 2972,2888,2552,2392,2364,1832 and 1140 nm stretching frequency when compared with the standard. The IR stretching frequency at 2888 nm was due to the Methyne CH stretching frequency. The band at 2552 nm was due to Thiol group present. A strong peak at 1832 nm represented to aromatic combination bands,open chain acid anhydride, five-membered ring anhydride and transition metal carbonyls. Nonappearance of any peak at 2260 nm region indicated the absence of cyanide group in the extract an important character of nontoxic nature of the plants. A peak at 1140 nm confirmed the presence of sulfur-containing sulfonates, silicate, Dialkyl/aryl sulfone and skeletal C-C vibrations. The results indicated the presence of tannins, flavonoids and phenols.

Fig. 5: FTIR spectrum analysis of methanolic extract of P. tithymaloides
Results of Rhoeo discolor FTIR spectroscopic studies (fig. 6) revealed the presence of various chemical constituents in the extract of with various peaks values corresponding with 3420, 3010, 2930, 2860, 2420, 2378, 1740, 1616, 1350, 1308 and 1028 nm stretching frequency when compared with the standard. The IR stretching frequency at 3420 nm could be due to the secondary aromatic amine NH stretching frequency. The band at 2930 nm was due to Methyne CH stretching. A strong peak at 1616 nm assigned Alkenyl C=C stretching,aromatic ring stretching,secondary amine and NH bend group which was primarily associated with amides. Nonappearance of any peak at 2260 cm-1 region indicated the absence of cyanide group in the extract which showed nontoxic nature of the plants. A peak at 1350, 1308 and 1028 nm confirmed the presence of sulfur-containing sulfonates, silicate, organic phosphate, 1 ° and 2 ° OH bond, aliphatic and aromatic nitro compounds, Dialkyl/aryl sulfone and skeletal C-C vibrations. The overall spectrum analysis indicated the presence of phytosterols, phenols, multi phenolic groups (Tannins) and terpenoids.

Fig. 6: FTIR spectrum analysis of methanolic extract of Rhoeo discolour
In the case of Tradescentia zebrine FTIR spectrum (fig. 7), the intense bands occurred at 2972 and 2888 stretching indicated the presence of Methyne CH stretching. A strong peak at 1804 nm giving aromatic combination bands,acid halide, transition metal carbonyl and open chain acid anhydride stretching in FTIR corresponded to OH group which confirmed the presence of phenolic compounds in leaf extract of zebrina. The peak at 1280 corresponded to organic phosphates, organic nitrates, phenol C-O stretch and 1 ° as well as 2 ° amine CN stretch along with OH in-plane bend. A peak at 1238 indicated skeletal C-C vibrations, aromatic ethers, aryl-O stretch Peak at 1098 corresponded to sulfate ion, phosphate ion, organic siloxane. Thus, The FTIR spectrum confirmed the presence of phenols, amino acids, amides, carboxylic acids, alkanes, aliphatic esters, secondary alcohols, sulfur compounds and monosubstituted alkenes along with Tannins, terpenes, and flavonols in aqueous leaf extract of Tradescentia zebrine (fig. 7).

Fig. 7: FTIR spectrum analysis of methanolic extract of Tradescentia zebrine
The phytochemical analyses further analyzed with FTIR and the graphs were compared. The FTIR analysis results were in support of biochemical assay results
Antibiotic activity of the selected non-flowering indoor plants
Antibiotic Sensitivity Testing for the 4 nonflowering croton species showed a characteristic pattern of inhibition against Escherichia coli and E. fecalis which differed amongst the four species (fig. 8-A). P. Tithymaloides (2) showed a maximum zone of inhibition followed by C. terminalis (1) with considerable control while (3) R. discolor and (4) T. zebrina have a smaller zone of inhibition on growth of Escherichia coli. In contrast, C. terminalis (1) plant extract showed a faint zone of inhibition against E. fecalis (fig. 8B). The extracts of R. discolour showed antimicrobial activity against Ecoli and least activity against P. aeruginosa and Candida albicans [9]. Higher concentration of C. terminalis (500µg/ml) showed a moderate antimicrobial activity against (>11 mm) against E. Coli, Shigella boydii, Streptococcus pyogenes and Staphylococcus epidermis [25]
Dyeing properties of the selected croton leaf extract on the fabric material
The pretreated cloth (initially treated with mordant i. e tannic acid) subjected to dyeing for a particular period of time followed by stannous chloride gave rise to colours. The shades of muslin cloth colour depended on the leaf extract (fig. 9). Cloth treated with P. tithymaloides leaf extract (prepared in 20%methanol) dyed with brownish orange colour and retained the colour even after subjecting it to sunlight. Cordyline terminalis leaf extract gave rise to a dark purple and green combination of colours. In contrast, the cloth stained with methanolic extract of Tradescentia zebrine showed bright purple colour when compared to the boiled extra
The muslin cloth is treated with different plant leaf extracts 1. Pedilanthus tithymaloides (20% methanol), 2-Cordyline terminalis, 3-Rhoeo discolour, 4-Mordant treated muslin cloth 5-T. Zebrine (20% methanol) and 6-boiled aquatic T. zebrina plant leaf extracts.
Fig. 8: Antibiotic sensitivity testing using the leaf extracts of selected plants (1. C. terminalis, 2. Pedilanthus tithymaloides, 3. R. Discolour, 4. T. zebrina) against (A) Escherichia coli and (B) E. fecalis

Fig. 9: Fabric material treated with the four different plant extracts
pH variation
Extractions of leaves of Cordyline terminalis and Rhoeo discolor were considered the acid-base indicator identification. Standard solutions (different concentrations of HCl, NaOH and NaCl solutions to provide a pH range of 1-13) were added to 1 or more drops of the extracts and the ability of different extracts to differentiate pH ranges was compared.
Methanolic C. terminalis extract is bright green in colour at pH 7.2 On addition of 0.1 N HCL the plant extract turns to red at approx. pH 5.4 whereas bright green turns into moss green as an alkali is added the colour turns to dull green T. zebrina plant extract also showed pH variation on the addition of acid and alkali which lead to changes in the pH. Alkaline additions change the bright green plant extract to dull green and acids change from bright green to light orange colour leading to a change in pH.
Various shades of colour were exhibited by the dyed fabrics depending on the leaf extract used to dye. Brownish orange colour (P. tithymaloides) and a dark purple and green combination (C. Terminalis) were predominant colours followed by bright purple colour (Methanolic extract of Tradescentia zebrine) were incorporated by leaf extracts. Cordyline terminalis and Rhoeo discolor extracts proved to be good acid-base indicator.


Fig. 10: pH variation of (1) C terminalis (methanolic) and (2) T. zebrina extracts
CONCLUSION
Few studies have been undertaken on some species of the non-flowering indoor plants as antibiotic [26]. The antimicrobial studies with respect to indoor atmospheric conditions with respect to control the mold, bacterial spores and other harmful microbes was well noted due to the volatile compounds that release into the atmosphere [27] The current study is unique of its own, due to the aspects that were taken into consideration such as phytochemical analyses, antioxidant characteristics as well as their economic importance. Indoor non-flowering leaf extracts showed a quality of phytochemicals such as tannins, phenols, flavonols and sterols which were supported by FTIR spectrum analyses in abundant quantities. The antioxidant potential of the methanolic extracts (FRAP analysis) may be due to the presence of tannins and phenolic compounds. The study revealed the analytical importance of various plant extracts as acid-base indicator against harmful, costly and hazardous synthetic indicators for titrimetry analysis as well as cheap dyes. There were no such studies undertaken till now all over the world except their vegetative propagation and the environmental studies. Indoor ornamental plants can offer sources for pharmacy and phytotherapy in future along with high aesthetic value where research is required.
ACKNOWLEDGEMENT
The authors thank their SVKM management for providing good working conditions, Principal Rajpal Hande for his encouragement and Dr. DVKamat for his constant support throughout this project.
CONFLICT OF INTERESTS
Declare none
REFERENCES
How to cite this article